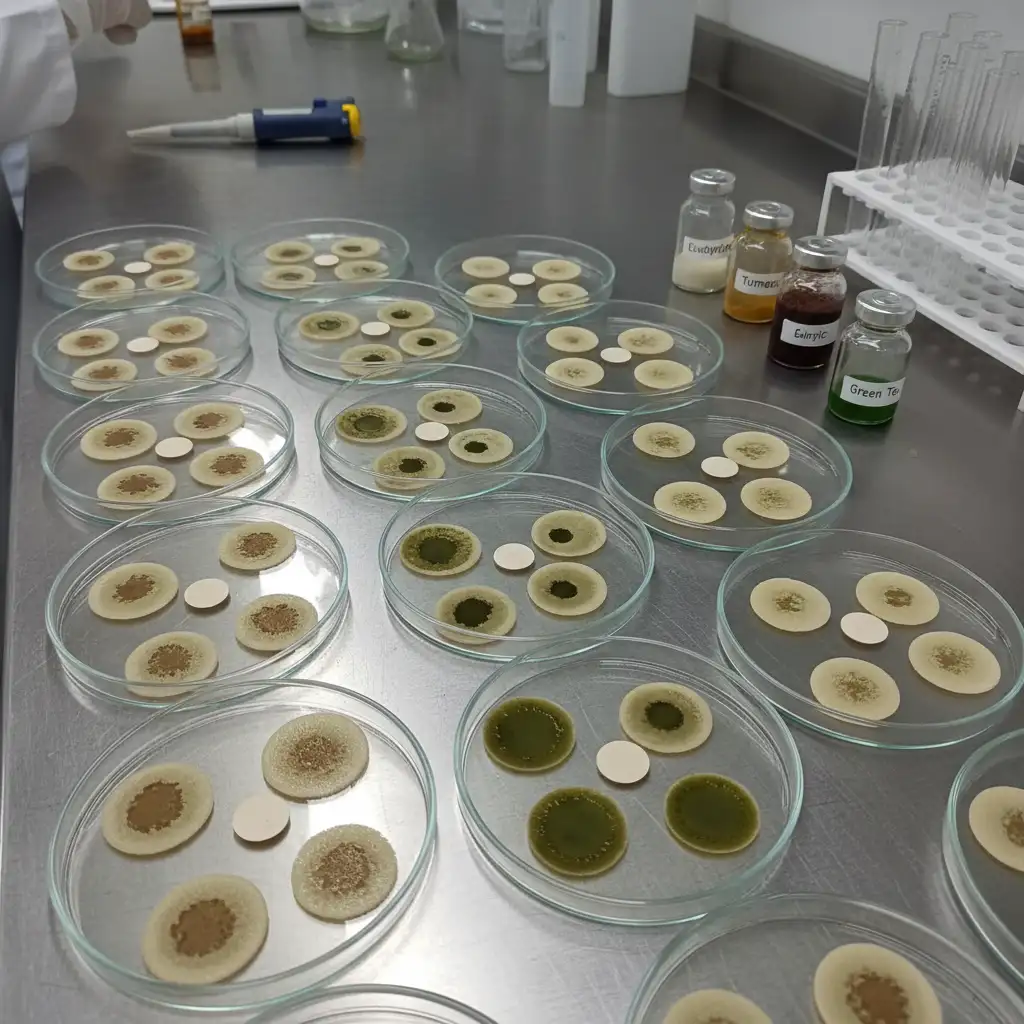
Laboratory testing of antimicrobial properties in petri dishes

Kawakawa scientific research primarily focuses on validating the pharmacological activities of Piper excelsum, specifically its anti-inflammatory, antimicrobial, and analgesic properties attributed to bioactive compounds like myristicin and diayangambin. Current academic studies aim to bridge traditional Rongoā Māori knowledge with evidence-based medicine to establish safety profiles, efficacy mechanisms, and standardized therapeutic applications for this endemic New Zealand plant, with more resources available on our Home page.
Overview of Published Research on Piper excelsum
Kawakawa (Piper excelsum), often referred to as the New Zealand Pepper Tree, holds a central place in Rongoā Māori (traditional Māori medicine). While its cultural and historical usage is well-documented, Kawakawa scientific research has gained significant momentum in recent decades as pharmacologists and botanists seek to understand the mechanisms behind its healing reputation. Unlike its close relative Kava (Piper methysticum), Kawakawa does not contain kavalactones but possesses a distinct chemical profile that has intrigued researchers at institutions such as the University of Auckland and the University of Otago.
The transition from traditional knowledge to clinical validation involves rigorous scrutiny. Early research largely focused on botanical classification and ethnomedicine surveys, including studies on Pūhā: Nutritional Value and Health Benefits. However, modern studies have shifted toward phytochemical analysis, isolating specific compounds to test their efficacy in in vitro (test tube) and in vivo (living organism) models. The primary goal of this research is to substantiate claims regarding the plant’s ability to treat inflammation, skin infections, gastrointestinal upset, and neural pain.

Currently, the body of literature suggests that Kawakawa is not merely a placebo but a pharmacologically active agent. Researchers are particularly interested in the variation of chemical markers depending on the plant’s geography (chemotypes) and the extent of predation by the Kawakawa looper moth (Cleora scriptaria), which is believed to trigger an increase in the plant’s defense chemicals, thereby enhancing its medicinal potency.
Key Bioactive Compounds: Myristicin and Diayangambin
To understand the therapeutic potential of Kawakawa, one must examine its phytochemistry. Scientific analysis using gas chromatography-mass spectrometry (GC-MS) has identified several dominant bioactive constituents. The most significant among these are myristicin, elemicin, and diayangambin.
Myristicin
Myristicin is a phenylpropene organic compound also found in nutmeg and parsley. In Piper excelsum, it is a major constituent of the essential oil found in the leaves. Research indicates that myristicin acts as a serotonin receptor antagonist and possesses anti-inflammatory properties. However, it is also the compound responsible for potential toxicity if consumed in extremely high quantities, known to cause psychoactive effects and hepatotoxicity in massive doses. In the context of Kawakawa tea or balms, the concentration is generally considered therapeutic rather than toxic, but it remains a focal point for safety studies.
Diayangambin
Perhaps the most exciting discovery in Kawakawa scientific research is the presence of diayangambin. This lignan has demonstrated significant immunosuppressive and anti-inflammatory activity in laboratory settings. Studies suggest that diayangambin can inhibit the proliferation of T-lymphocytes and reduce the production of pro-inflammatory cytokines. This provides a plausible biological mechanism for the traditional use of Kawakawa in treating eczema, rheumatism, and other inflammatory conditions.
Anti-inflammatory and Analgesic Properties
The most widely recognized application of Kawakawa is for pain relief and reducing inflammation. Scientific investigations have sought to quantify this effect. In studies assessing the anti-inflammatory activity of Piper excelsum leaf extracts, researchers have observed a reduction in nitric oxide production in activated macrophages. Nitric oxide is a key signaling molecule in the inflammatory process; by inhibiting its production, Kawakawa extracts effectively dampen the inflammatory response.
Furthermore, the analgesic (pain-killing) properties are linked to the structural similarity of some of its compounds to known analgesics. While it does not function as an opiate, the modulation of inflammatory pathways contributes to pain reduction. This is particularly relevant for its topical use in balms for joint pain, bruises, and neuralgic pain like toothaches.
One notable study compared the efficacy of Kawakawa extracts against standard anti-inflammatory drugs in laboratory models. While the herbal extract may not always match the potency of synthetic pharmaceuticals like ibuprofen, it offers a multi-targeted approach with potentially fewer gastric side effects, provided the dosage is controlled. For more details on the general classification of these plants, you can refer to authoritative sources like Wikipedia’s entry on Piper excelsum.
Antimicrobial Activity and Traditional Uses
Rongoā Māori has long utilized Kawakawa for treating cuts, wounds, and venereal diseases, implying strong antimicrobial capabilities. Modern microbiology has put these claims to the test. Extracts of Kawakawa have been screened against a panel of common pathogens, including Staphylococcus aureus, Escherichia coli, and Candida albicans.
The results have been promising, though variable. The essential oils derived from the leaves have shown moderate antibacterial activity, particularly against Gram-positive bacteria like S. aureus. This supports the traditional practice of using heated leaves as Poultices and Compresses from Native Plants for Skin and Muscle Ailments on boils and infected wounds. The hydrophobic nature of the essential oils allows them to penetrate bacterial cell membranes, disrupting their integrity.
However, scientific consensus emphasizes that while Kawakawa is antiseptic, it is not a replacement for antibiotics in severe systemic infections. Its utility is best supported in topical applications for minor skin infections and as a gargle for oral hygiene, where it helps manage bacterial load and soothe mucosal inflammation.
Cytotoxicity and Anticancer Potential
A burgeoning area of Kawakawa scientific research is the investigation into its cytotoxic effects—its ability to kill cells, specifically cancer cells. The compound diayangambin, along with other lignans found in the plant, has been screened for antitumor activity.
Preliminary in vitro studies indicate that certain extracts of Piper excelsum can induce apoptosis (programmed cell death) in specific cancer cell lines. However, it is critical to interpret these findings with caution. “Cytotoxicity” in a petri dish does not translate directly to a cancer cure in humans. High cytotoxicity can also imply damage to healthy cells if the compound is not selective.
Current research is focused on fractionation—separating the complex mixture of the plant extract into individual components to identify which molecules are responsible for the antiproliferative effects. This could eventually lead to the development of novel therapeutic agents, but this area of study is still in its infancy compared to the established anti-inflammatory research.
Dosage, Safety, and Potential Drug Interactions
As the market for Kawakawa tea, tonics, and supplements grows, establishing safety parameters is paramount. Natural does not always mean safe, and the presence of myristicin warrants careful consideration regarding dosage.
Myristicin Toxicity Risks
Myristicin is known to inhibit monoamine oxidase (MAO), an enzyme that breaks down neurotransmitters. While the levels in a standard cup of Kawakawa tea are generally safe for healthy adults, excessive consumption could theoretically lead to dizziness, confusion, or tachycardia. There is also a theoretical risk of hepatotoxicity (liver damage) if consumed in concentrate forms over long periods, although this is less documented in Kawakawa than in Kava (Piper methysticum).
Drug Interactions
Because myristicin is a mild MAO inhibitor, there is a potential for interaction with antidepressant medications, specifically MAOIs and SSRIs. Combining Kawakawa with these drugs could theoretically increase the risk of serotonin syndrome, a serious condition caused by excessive serotonin accumulation. Furthermore, because Kawakawa can affect liver enzymes (Cytochrome P450), it may alter the metabolism of other pharmaceuticals.

Recommended Usage
Standardized dosing guidelines for Kawakawa do not currently exist in a pharmaceutical sense. However, traditional guidance and modern herbal practice suggest:
- Infusions (Tea): Limiting consumption to 2-3 cups daily.
- Duration: Taking breaks after 2 weeks of daily use to reduce liver load.
- Pregnancy: Caution is advised due to the lack of clinical trials confirming safety for the fetus; many herbalists recommend avoiding it during the first trimester.
Future Directions in Kawakawa Pharmacology
The future of Kawakawa scientific research lies in human clinical trials. Most data currently relies on chemical analysis and animal or cellular models. To fully integrate Kawakawa into the broader healthcare system, randomized controlled trials are necessary to confirm efficacy for specific conditions like dyspepsia or eczema.
Additionally, agricultural research is focusing on the sustainable harvesting of Kawakawa. As demand increases, understanding the impact of harvesting methods on the plant’s regeneration and chemical profile is vital to ensure that the Rongoā remains available for future generations. For further reading on New Zealand’s flora, the Manaaki Whenua – Landcare Research databases provide extensive botanical information.
In conclusion, the scientific validation of Kawakawa is a testament to the sophistication of Rongoā Māori. The evidence supports its use as a potent anti-inflammatory and antimicrobial agent, provided it is used with respect for its chemical potency and safety limitations.
People Also Ask
Is kawakawa scientifically proven to work?
Yes, scientific studies have identified bioactive compounds in kawakawa, such as diayangambin and myristicin, which have demonstrated anti-inflammatory, antimicrobial, and analgesic effects in laboratory settings, supporting its traditional medicinal uses.
What are the side effects of kawakawa?
When consumed in moderation, side effects are rare. However, excessive consumption may cause gastrointestinal discomfort, numbness in the mouth, or potential liver stress due to the compound myristicin. It may also interact with certain medications.
Does kawakawa contain myristicin?
Yes, kawakawa (Piper excelsum) contains myristicin, a phenylpropene compound. While it contributes to the plant’s therapeutic effects, it can be toxic in extremely high doses, which is why moderation is recommended.
Is kawakawa good for inflammation?
Research indicates that kawakawa is effective for inflammation. The compound diayangambin found in the leaves has been shown to inhibit pro-inflammatory cytokines, making it useful for skin conditions, joint pain, and general inflammation.
Can you drink kawakawa tea every day?
While many people drink it daily, herbalists often recommend limiting intake to 2-3 cups a day and taking a break after two weeks of continuous use to prevent any potential cumulative toxicity or liver stress.
What is the Latin name for kawakawa?
The scientific Latin name for kawakawa is Piper excelsum. It was formerly known as Macropiper excelsum before being reclassified into the genus Piper.



